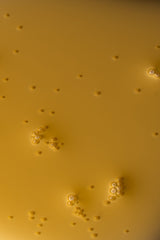
Day Serum

Day Serum
Day Serum is backordered and will ship as soon as it is back in stock.
Learn more
Learn more
Your daily dose of botanical nourishment. This luxurious blend of camellia seed, rosehip, and evening primrose oils, enhanced with frankincense, lavender, and vitamin E, absorbs effortlessly to reveal soft, luminous skin. The perfect start to your skincare ritual.
Ingredients
Ingredients
Why we ship differently
Why we ship differently
At Awear, we choose people over speed.
Many of our brands are small, American-owned businesses that ship thoughtfully, sustainably, and in smaller batches. That means delivery may take a little longer — and shipping costs can vary.
Select brands are able to offer free shipping, but for most of our makers, every order is packed and sent with care by real people, not warehouses. Click here to see all our Free Shipping Brands.
And because we want it to be easier to shop small: spend over $89 and your shipping is free.
Your patience supports small businesses, ethical production, and a more intentional way of shopping. We’re so grateful you’re here.
A NOTE FROM AWEAR
Your Healthy Journey Starts With Just One Thing
DAVE COULIER, FOUNDER
Share your favorites with @awear.market